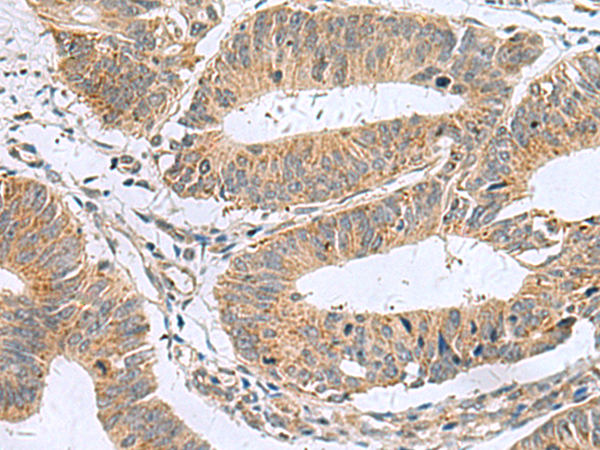
一抗

中文名稱: 兔抗MARCKSL1多克隆抗體
英文名稱: Anti-MARCKSL1 rabbit polyclonal antibody
別 名: MARCKS like 1; F52; MLP; MRP; MLP1; MACMARCKS
相關(guān)類別: 一抗
儲(chǔ) 存: 冷凍(-20℃)
宿 主: Rabbit
抗 原: MARCKSL1
反應(yīng)種屬: Human, Mouse, Rat
標(biāo) 記 物: Unconjugate
克隆類型: rabbit polyclonal
技術(shù)規(guī)格
|
Background: |
This gene encodes a member of the myristoylated alanine-rich C-kinase substrate (MARCKS) family. Members of this family play a role in cytoskeletal regulation, protein kinase C signaling and calmodulin signaling. The encoded protein affects the formation of adherens junction. Alternative splicing results in multiple transcript variants. Pseudogenes of this gene are located on the long arm of chromosomes 6 and 10. |
|
Applications: |
ELISA, WB, IHC |
|
Name of antibody: |
MARCKSL1 |
|
Immunogen: |
Fusion protein of human MARCKSL1 |
|
Full name: |
MARCKS like 1 |
|
Synonyms: |
F52; MLP; MRP; MLP1; MACMARCKS |
|
SwissProt: |
P49006 |
|
ELISA Recommended dilution: |
5000-10000 |
|
IHC positive control: |
Human colorectal cancer |
|
IHC Recommend dilution: |
50-100 |
|
WB Predicted band size: |
20 kDa |
|
WB Positive control: |
RAW264.7 cell lysate |
|
WB Recommended dilution: |
500-2000 |


 購(gòu)物車
購(gòu)物車 幫助
幫助
 021-54845833/15800441009
021-54845833/15800441009